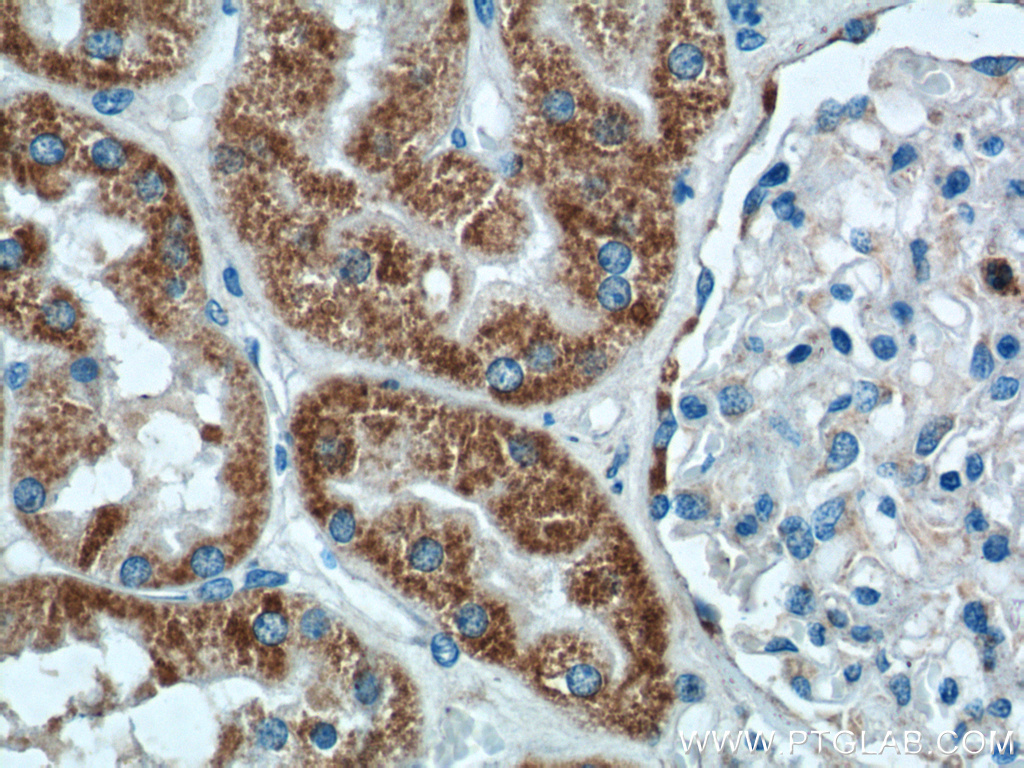

验证数据展示
经过测试的应用
| Positive WB detected in | HeLa cells, NIH/3T3 cells |
| Positive IP detected in | HeLa cells |
| Positive IHC detected in | human kidney tissue, mouse kidney tissue, mouse stomach tissue, rat kidney tissue Note: suggested antigen retrieval with TE buffer pH 9.0; (*) Alternatively, antigen retrieval may be performed with citrate buffer pH 6.0 |
| Positive IF/ICC detected in | HeLa cells |
推荐稀释比
| 应用 | 推荐稀释比 |
|---|---|
| Western Blot (WB) | WB : 1:1000-1:8000 |
| Immunoprecipitation (IP) | IP : 0.5-4.0 ug for 1.0-3.0 mg of total protein lysate |
| Immunohistochemistry (IHC) | IHC : 1:100-1:400 |
| Immunofluorescence (IF)/ICC | IF/ICC : 1:50-1:500 |
| It is recommended that this reagent should be titrated in each testing system to obtain optimal results. | |
| Sample-dependent, Check data in validation data gallery. | |
产品信息
17984-1-AP targets AIF in WB, IHC, IF/ICC, IP, ELISA applications and shows reactivity with human, mouse, rat samples.
| 经测试应用 | WB, IHC, IF/ICC, IP, ELISA Application Description |
| 文献引用应用 | WB, IHC, IF |
| 经测试反应性 | human, mouse, rat |
| 文献引用反应性 | human, mouse, rat, pig, canine, sheep |
| 免疫原 |
CatNo: Ag12400 Product name: Recombinant human AIF protein Source: e coli.-derived, PET28a Tag: 6*His Domain: 259-609 aa of BC111065 Sequence: TPRSLSAIDRAGAEVKSRTTLFRKIGDFRSLEKISREVKSITIIGGGFLGSELACALGRKARALGTEVIQLFPEKGNMGKILPEYLSNWTMEKVRREGVKVMPNAIVQSVGVSSGKLLIKLKDGRKVETDHIVAAVGLEPNVELAKTGGLEIDSDFGGFRVNAELQARSNIWVAGDAACFYDIKLGRRRVEHHDHAVVSGRLAGENMTGAAKPYWHQSMFWSDLGPDVGYEAIGLVDSSLPTVGVFAKATAQDNPKSATEQSGTGIRSESETESEASEITIPPSTPAVPQAPVQGEDYGKGVIFYLRDKVVVGIVLWNIFNRMPIARKIIKDGEQHEDLNEVAKLFNIHED 种属同源性预测 |
| 宿主/亚型 | Rabbit / IgG |
| 抗体类别 | Polyclonal |
| 产品类型 | Antibody |
| 全称 | apoptosis-inducing factor, mitochondrion-associated, 1 |
| 别名 | AIFM1, PDCD8, EC:1.6.99.-, Apoptosis-inducing factor 1, mitochondrial |
| 计算分子量 | 609 aa, 66 kDa |
| 观测分子量 | 67 kDa, 57 kDa |
| GenBank蛋白编号 | BC111065 |
| 基因名称 | AIF |
| Gene ID (NCBI) | 9131 |
| RRID | AB_2224539 |
| 偶联类型 | Unconjugated |
| 形式 | Liquid |
| 纯化方式 | Antigen affinity purification |
| UNIPROT ID | O95831 |
| 储存缓冲液 | PBS with 0.02% sodium azide and 50% glycerol, pH 7.3. |
| 储存条件 | Store at -20°C. Stable for one year after shipment. Aliquoting is unnecessary for -20oC storage. |
背景介绍
Apoptosis-inducing factor (AIF) is one of the mitochondrial proteins to be released into the cytosol during apoptosis, and it is discovered as the first protein that regulates caspase-independent apoptosis(PMID:20494118). AIF is encoded as a 67 kDa protein that contains a mitochondrial localization signal (MLS) in the N-terminus.It is cleaved from the 62 kDa to the 57 kDa form following ischemic injury and translocated from the mitochondria to the nucleus in a calpain-dependent manner(PMID: 25101006).
实验方案
| Product Specific Protocols | |
|---|---|
| IF protocol for AIF antibody 17984-1-AP | Download protocol |
| IHC protocol for AIF antibody 17984-1-AP | Download protocol |
| IP protocol for AIF antibody 17984-1-AP | Download protocol |
| WB protocol for AIF antibody 17984-1-AP | Download protocol |
| Standard Protocols | |
|---|---|
| Click here to view our Standard Protocols |
发表文章
| Species | Application | Title |
|---|---|---|
Cell Rep Newly synthesized AIFM1 determines the hypersensitivity of T lymphocytes to STING activation-induced cell apoptosis
| ||
Phytomedicine LC-MS based metabonomics study on protective mechanism of ESWW in cerebral ischemia via CYTC/Apaf-1/NDRG4 pathway | ||
Oxid Med Cell Longev miRNA-27a Transcription Activated by c-Fos Regulates Myocardial Ischemia-Reperfusion Injury by Targeting ATAD3a. | ||
Elife Genome-wide CRISPRi screening identifies OCIAD1 as a prohibitin client and regulatory determinant of mitochondrial Complex III assembly in human cells. | ||
PLoS Pathog GP73 represses host innate immune response to promote virus replication by facilitating MAVS and TRAF6 degradation. | ||
J Med Chem Anticancer Effects of Honokiol via Mitochondrial Dysfunction Are Strongly Enhanced by the Mitochondria-Targeting Carrier Berberine. |